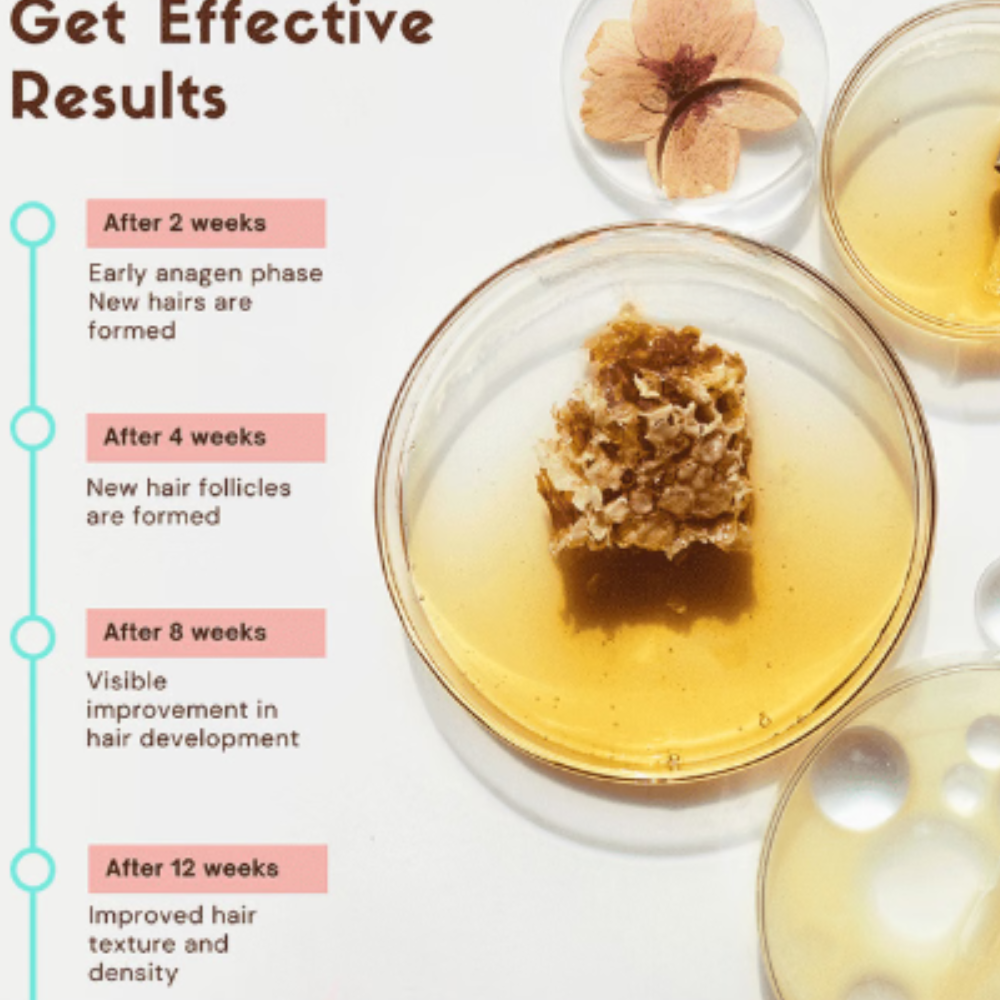
Coco Crush Hair Growth Serum - Image 3

Coco Crush Hair Growth Serum
₹235.00
Product highlights
Awakens sleeping hair stem cells for hair growth
Regulates hair lifecycle and fights hair loss
Stimulates hair follicles for growth in most needed areas of the scalp
Description
Information about Coco Crush Hair Growth Serum
Coco Crush Hair Growth Serum:
Coco Crush Hair Growth Serum Experience the power of nature with this natural Ayurvedic hair growth serum, enriched with blackseed oil, rosemary oil, virgin coconut oil, alkanet root, and almond oil. This potent serum is formulated to nourish and strengthen your hair and increase the volume of your hair, naturally. This serum is made using ancient Ayurvedic principles, combined with modern scientific research, to create a unique formula that nourishes and strengthens your hair from root to tip. The ingredients are carefully sourced and combined in precise proportions to ensure maximum effectiveness.
Key Ingredients:
Rosemary Oil, Peppermint Oil, Virgin Coconut Oil, Alkanet root (Ratanjot), Blackseed Oil (Kalonii), Sesame Oil, Castor Oil, Sweet Almond Oil
Key Benefits:
Stop hair loss: This ayurvedic hair growth serum helps nourish and strengthen your hair for a healthier appearance
Increase volume: Enriched with blackseed oil, rosemary oil, virgin coconut oil, alkanet root, and almond oil, our serum helps increase the volume of your hair, giving you fuller and thicker hair
Natural: This serum is made using only natural ingredients, free from harsh chemicals and additives, making it safe and gentle for all hair types
Ayurvedic formula: This serum is based on ancient Ayurvedic principles, combined with modern scientific research, to create a unique formula that nourishes and strengthens your hair from root to tip
Nourishing and strengthening: The potent blend of natural oils and herbs nourishes and strengthens your hair, promoting healthy hair growth and preventing breakage
Suitable for all hair types: This ayurvedic hair growth serum is suitable for all hair types, including curly, straight, and wavy hair, and can be used by both men and women
Suitable For:
all hair types
men
women
Directions For Use:
Simply apply a small amount of serum to your scalp and massage gently, leaving it on for a few hours or overnight before washing it off
Use regularly for best results
Safety Information:
Store it in a cool and dry place
Keep it away from direct sunlight
Keep it away from the reach of the children

Reviews
There are no reviews yet.